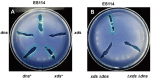

Correction for Fidopiastis et al., " Vibrio fischeri Possesses Xds and Dns Nucleases That Differentially Influence Phosphate Scavenging, Aggregation, Competence, and Symbiotic Colonization of Squid"
- PMID: 38712953
- PMCID: PMC11218643
- DOI: 10.1128/aem.00327-24
Correction for Fidopiastis et al., " Vibrio fischeri Possesses Xds and Dns Nucleases That Differentially Influence Phosphate Scavenging, Aggregation, Competence, and Symbiotic Colonization of Squid"
Figures

Erratum for
-
Vibrio fischeri Possesses Xds and Dns Nucleases That Differentially Influence Phosphate Scavenging, Aggregation, Competence, and Symbiotic Colonization of Squid.Appl Environ Microbiol. 2022 Nov 22;88(22):e0163522. doi: 10.1128/aem.01635-22. Epub 2022 Nov 7. Appl Environ Microbiol. 2022. Corrected and republished in: Appl Environ Microbiol. 2024 Jun 18;90(6):e0032824. doi: 10.1128/aem.00328-24. PMID: 36342139 Free PMC article. Corrected and republished.
Publication types
Grants and funding
LinkOut - more resources
Full Text Sources